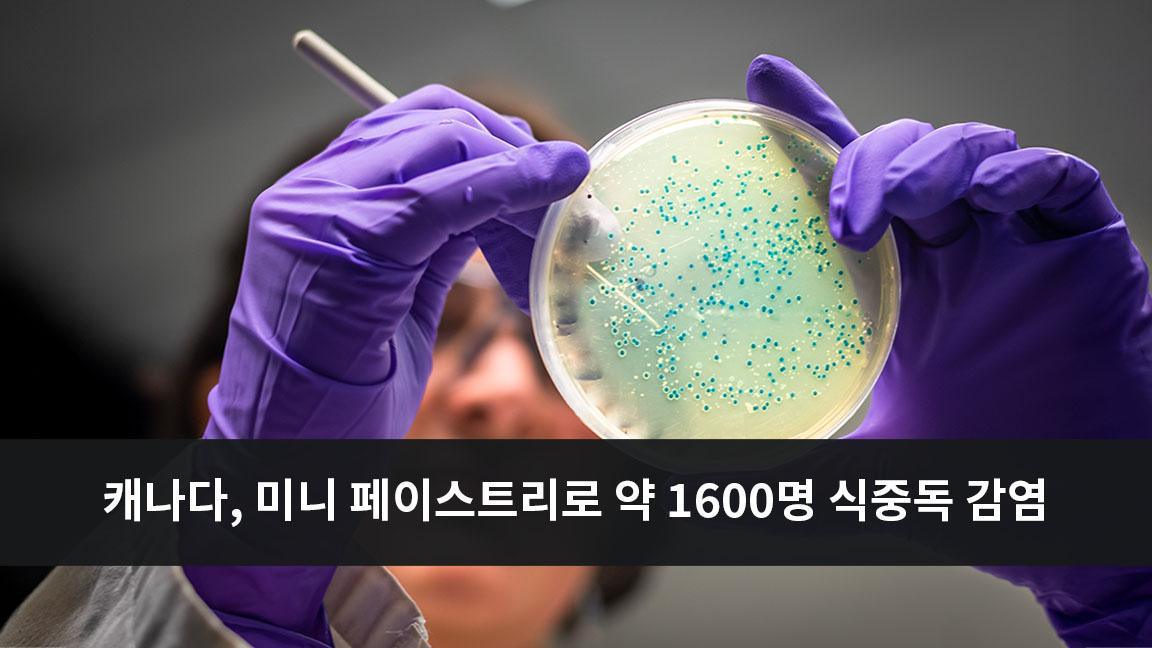
캐나다, 미니 페이스트리로 인해 약 1600명 식중독 감염 캐나다, 미니 페이스트리로 인해 약 1600명 식중독 감염

캐나다 공중보건국은 미니 페이스트리 리콜과 관련하여 약 1,600명이 살모넬라균에 의한 식중독에 감염되었을 수 있다고 밝혔습니다.
연방 기관의 발병 관리 책임자인 에이프릴 헥세머는 보고된 사례에 대해 발표하며 지역 사회에 26.1명이 더 있다는 기관의 추정에 근거하여 이와 같이 계산했다고 말하며 “우리는 1,592명이 이 사건의 영향을 받은 것으로 추정합니다. 우리가 알지 못하는 사람들은 경증 또는 중증의 증상을 보였을 수 있으며, 치료를 받지 않고 집에서 해결했을 수도 있습니다."라고 덧붙였습니다.
공중보건국은 지난 주말 빵집, 호텔, 레스토랑, 카페테리아, 병원, 양로원, 케이터링 행사에서 제공된 스위트 크림 브랜드의 미니 페이스트리와 관련된 살모넬라균 61건이 발생했다는 내용의 발병 공지를 발표했습니다.
리콜된 페이스트리는 생산을 중단한 이탈리아 제조업체에서 수입한 제품입니다.
헥세머는 공중보건국이 12월 12일 조사를 시작했으며 감염된 사람들 중 이례적으로 많은 수가 각종 디저트를 제공하는 케이터링 행사에 참석했다는 사실을 알아내고 케이터링 이벤트의 기록들을 추적하여 어떤 음식이 제공되었는지 확인한 결과 스위트 크림 브랜드의 미니 페이스트리가 제공된 것을 확인했다고 밝혔습니다
조사관들은 감염된 사람들의 표본을 검사한 결과 16건의 사례에서 식중독 균의 유전적 특징이 일치하는 것을 발견했으며, 이는 감염된 사람들이 동일한 제품에 노출되었다는 강력한 증거를 제공했습니다.
61명의 감염자 중 33명은 퀘벡, 21명은 온타리오, 4명은 브리티시 컬럼비아, 2명은 앨버타, 1명은 뉴브런즈윅에 거주했습니다. 헥세머는 해당 미니 패스트리가 노바스코샤주에서도 유통되었지만 월요일 오후 현재까지 노바스코샤주에서는 질병이 보고되지 않았다고 말했습니다.
헥세머는 감염된 사람이 질병을 신고하기까지 일반적으로 2~7주 정도 지연되기 때문에 더 많은 사례가 보고될 것으로 예상한다고 말했습니다.
캐나다와 미국에 이탈리아 제품을 유통하는 퀘벡 소재 피우 체 돌치의 수입 영업 매니저인 조셉 파네타는 모든 캐나다 고객으로부터 리콜된 제품을 수거하여 실험실로 보내 검사할 예정이고 미국 고객들은 리콜 제품으로 인한 살모넬라균의 영향을 받지 않았다고 밝혔습니다.